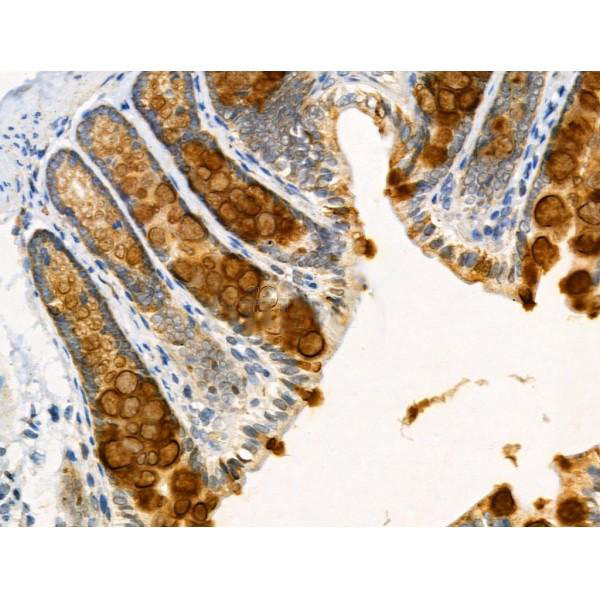

Catalyzes the synthesis of acetyl-CoA from short-chain fatty acids. Acetate is the preferred substrate. Can also utilize propionate with a much lower affinity (By similarity).
Description
Rabbit polyclonal antibody to ACSA
Applications
WB, IHC.
Immunogen
ACSA Antibody detects endogenous levels of total ACSA.
Reactivity
Human, Mouse, Rat.
可预测:Bovine(91%), Horse(91%), Sheep(91%), Rabbit(91%), Dog(91%), Chicken(82%)
Molecular weight
78 KD; 79kD(Calculated).
Host species
Rabbit
Ig class
Immunogen-specific rabbit IgG
Purification
Antigen affinity purification
Full name
ACSA
Synonyms
ACAS2; AceCS; Acetate CoA ligase; Acetate thiokinase; Acetate--CoA ligase; Acetyl CoA synthetase; Acetyl Coenzyme A synthetase 2 (ADP forming); Acetyl coenzyme A synthetase cytoplasmic; Acetyl-CoA synthetase; Acetyl-coenzyme A synthetase; ACS; ACSA; ACSA_HUMAN; ACSS2; Acyl activating enzyme; Acyl CoA synthetase short chain family member 2; Acyl-activating enzyme; Acyl-CoA synthetase short-chain family member 2; Cytoplasmic acetyl coenzyme A synthetase; cytoplasmic; MYH7B; AceCS1
Storage
Rabbit IgG in phosphate buffered saline , pH 7.4, 150mM NaCl, 0.02% sodium azide and 50% glycerol. Store at -20 °C. Stable for 12 months from date of receipt.
Swissprot
Q9NR19




 产品订购:
产品订购:
 渠道电话:
渠道电话: